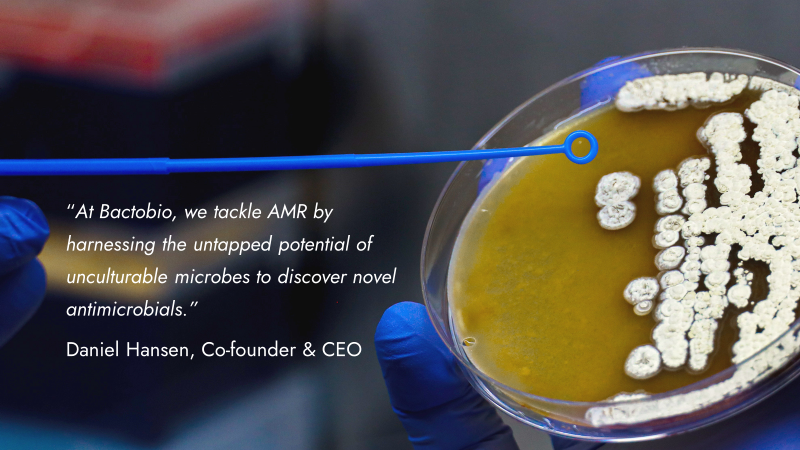
Bactobio tweet media

Bactobio
86 posts

@bactobio
Uncovering solutions from biological dark matter.













Potato Late Blight: Unlocking Microbial Solutions for Farmers free webinar 🥔 With speakers from @JamesHuttonInst, @bactobio and CHAP, this is a webinar that you cannot miss! 📅Monday 4 December 12pm - 2pm ➡️Find out more and book here: ow.ly/VgGz50Q6Y44 #agritech

The World AMR Awareness Week (#WAAW23) theme calls for cross-sectoral collaboration to preserve the effectiveness of antimicrobials. Check out our latest video displaying the collaboration between the Microbiology Society and industry partner @bactobio: microb.io/3QCIdzq




Last week, the team were at the @bactobio offices filming a video for a project about exploiting soil microbiomes to fight potato late blight Keep an eye on our channels for the video 👀 ➡️Find out more about the project here: ow.ly/55Ja50Q3XNg @lilacfilms

We're delighted to share our collaboration with industry partner @bactobio under our new #KnockingOutAMR project. Watch this video to learn how we're working together 🤝 microb.io/3QCIdzq and read the Dr Mark Wilkinson Q&A: microb.io/3QE0soc👈


